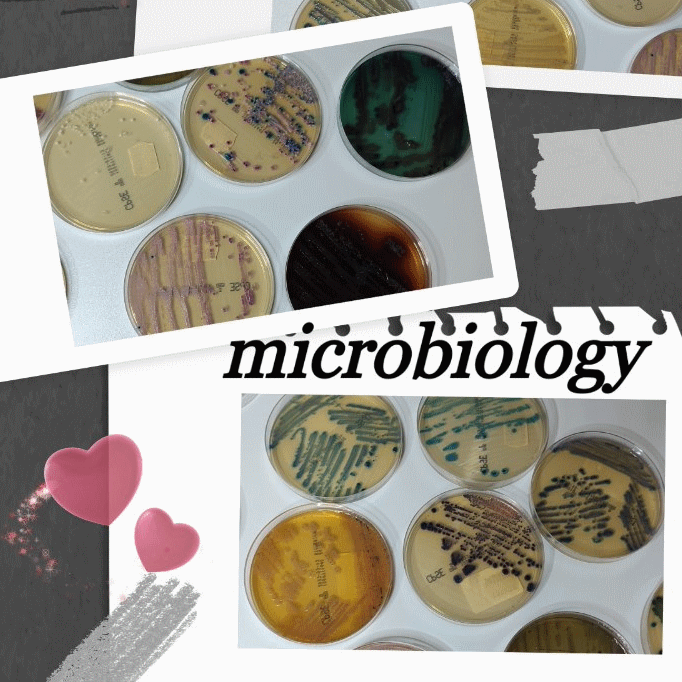

Hallo und Herzlich Willkommen in der spannenden Welt der Mikrobiologie
Lass dich von mir in die Welt der medizinischen Mikrobiologie entführen! Hier findest du Einsteiger- und Grundlagenkurse, die dich in die Materie einführen und dir die Basics vermitteln, die es braucht, um das große Ganze zu verstehen. Unter anderem gibt es auch einen tollen Chemiekurs für die medizinische Mikrobiologie. Tauche ein in die faszinierende Mikro-Welt!
Lass dich von mir in die Welt der medizinischen Mikrobiologie entführen! Hier findest du Einsteiger- und Grundlagenkurse, die dich in die Materie einführen und dir die Basics vermitteln, die es braucht, um das große Ganze zu verstehen. Unter anderem gibt es auch einen tollen Chemiekurs für die medizinische Mikrobiologie. Tauche ein in die faszinierende Mikro-Welt!
Course plan
Einführung medizinische Mikrobiologie
Crashkurs organische Chemie für Mikrobiologie